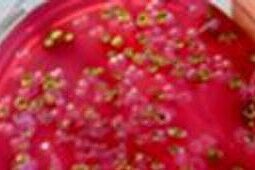

Food Science Dialog 2014 - Lebensmittelsicherheit & Verpackung
Lebensmittelsicherheit ist und bleibt eine der bedeutendsten Aufgaben des vorbeugenden Verbraucherschutzes und zieht sich durch die gesamte Lebensmittelkette, von der Primärerzeugung bis zu fertigen Produkt und darüber hinaus.
Die zunehmende Globalisierung schafft nicht nur neue Möglichkeiten, sondern auch neue Herausforderungen für alle Beteiligten. Um sich Letzeren zu stellen und diesen zu begegnen, ist ein stufenübergreifendes Netzwerk zur Risikominimierung unabdingbar. Dabei gewinnt die interdisziplinare Zusammenarbeit zur Weiterentwicklung und stetigen Verbesserung der Leistungsfähigkeit und fachlichen Kompetenz aller Akteure zunehmend an Bedeutung.
Die jährlich stattfindende Fortbildung im Rahmen des Food Science Dialogs Hamburg bietet die Möglichkeit zum multilateralen Erfahrungsaustausch und greift 2014 das Thema „Lebensmittelsicherheit und Verpackung“ auf. Der Dialog widmet sich an den ersten drei Tagen den Schwerpunkten Risiko-, Konflikt- und Krisenmanagement, der Lebensmittelinformationsverordnung sowie dem Tierschutz bei der Halal-Schlachtung. An den letzten beiden Tagen liegt der Fokus auf der Verpackung von Lebensmitteln.
Die Vorträge dieses Themenkomplexes informieren über die techno-funktionellen Aspekte sowie die Bedeutung der Verpackung für die Vermarktung von Lebensmitteln, die analytische Bewertung, Risikomanagement und -bewertung, rechtliche Regelungen sowie innovative Lösungsansätze mit multidimensionalem Mehrwert bzgl. der Lebensmittelsicherheit und der Lebens(mittel)qualität. Zudem stehen die Besichtigung der Firma Deiters & Florin, des Veterinär- und Einfuhramtes und des Verpackungsinstitutes BFSV auf dem diesjährigen Programm.
Das ausführliche Programm finden Sie im Programmflyer .
Der Food Science Dialog findet statt in Kooperation mit:
- der Hochschule für Angewandte Wissenschaften Hamburg
- der Behörde für Gesundheit und Verbraucherschutz Hamburg
- der Akademie für Öffentliches Gesundheitswesen Düsseldorf
Und in Zusammenarbeit mit:
- der Behörde für Wissenschaft und Forschung Hamburg
- sowie der Universität Wageningen (Niederlande)